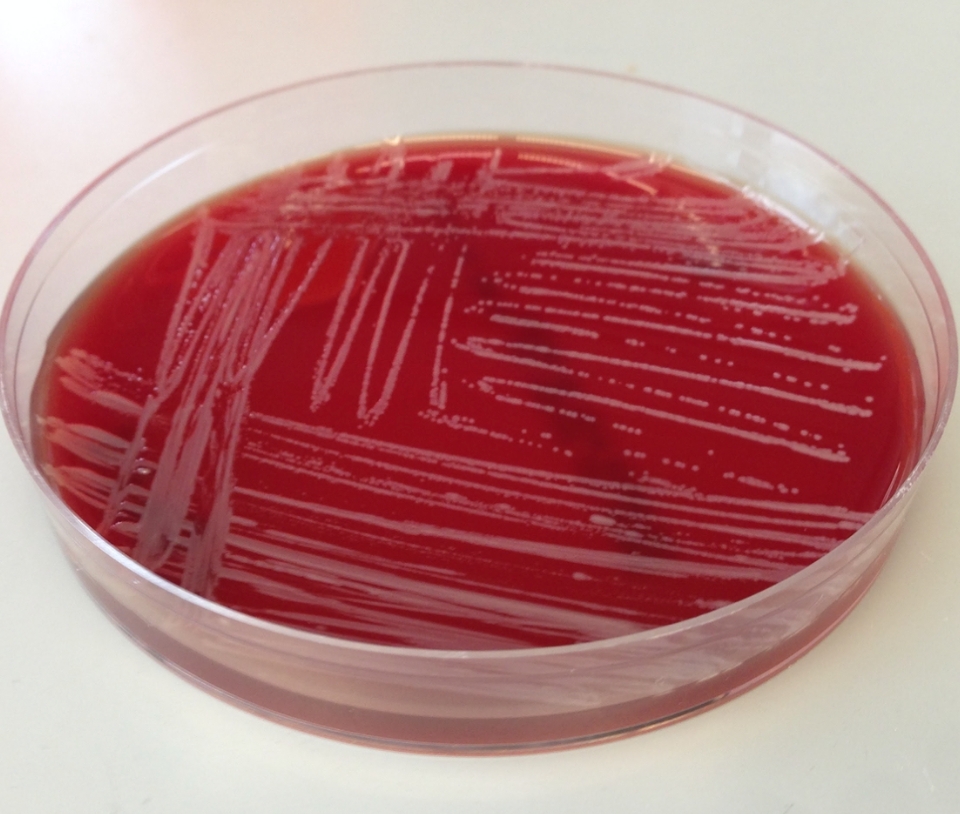

Contact us directly if you require assistance
Did you know: our service is free for all Canadian CF clinics and hospitals? Current turnaround time: ~8 days from time of sample receipt.
Click on the buttons below to contact us if you require assistance or to learn more about our work.
Our team can provide:
- Species identification for members of the Burkholderia cepacia complex of bacteria.
- Burkholderia cepacia 7-MLST Sequence Typing
- Strain typing information, as well as identifications for other species which grow on Burkholderia cepacia selective agar and for which the preliminary identification might be equivocal: such as B. gladioli, Ralstonia species, Pandoraea species and others. Most of our work is for cystic fibrosis clinics, however we are very happy to provide assistance to anyone else requiring identification of these bacteria.
- Bacterial isolates for research studies.
Please click the links above to find information about our services. If you have any questions, please contact us.
Request Isolates for Research
Isolates are available to researchers (both in academia and industry). Click on the button below to learn more.
Request IsolatesOur Research
Our goal is to contribute to improved outcomes in bacterial infections in people with cystic fibrosis. Click on the button below to learn more.